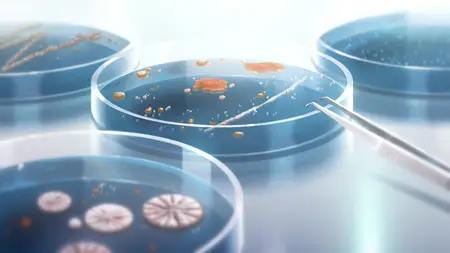

Almost Naked Animals S01e43 Stink Dog 1080p Amzn Web DL DD 2 0 H 264 Sigma
BBC.Documentaries.S1982E09.The.Rank.Charm.School.iP.WEB-DL.AAC.2.0.H.264-BTN-RakuvFIN S1982E09 TV Series
Posted by Tavaz at Aug. 1, 2018
BBC.Documentaries.S1982E09.The.Rank.Charm.School.iP.WEB-DL.AAC.2.0.H.264-BTN-RakuvFIN S1982E09
WEB-DL | MKV | 960x540 | H264 | AAC | 48 min 47 s | 670 MiB
WEB-DL | MKV | 960x540 | H264 | AAC | 48 min 47 s | 670 MiB
BBC.Documentaries.S1982E10.Survivalists.iP.WEB-DL.AAC.2.0.H.264-BTN S1982E10 TV Series
Posted by Tavaz at Aug. 1, 2018
BBC.Documentaries.S1982E10.Survivalists.iP.WEB-DL.AAC.2.0.H.264-BTN S1982E10
WEB-DL | MKV | 960x540 | H264 | AAC | 48 min 25 s | 667 MiB
WEB-DL | MKV | 960x540 | H264 | AAC | 48 min 25 s | 667 MiB
Ameku M D Doctor Detective S01E09 The Night When the Angels Danced Part 2 1080p AMZN WEB-DL Multi DDP2 0 x264 Anime
Posted by Otaku at April 28, 2025
Ameku M D Doctor Detective S01E09 The Night When the Angels Danced Part 2 1080p AMZN WEB-DL Multi DDP2 0 x264
MKV | 1920x1080 | 日本語 / हिन्दी / English | H264 @ 3316 kbps | E-AC-3 @ 224.0 kbps | 23 min 45 s | 678 MiB
Subtitles: English
MKV | 1920x1080 | 日本語 / हिन्दी / English | H264 @ 3316 kbps | E-AC-3 @ 224.0 kbps | 23 min 45 s | 678 MiB
Subtitles: English
Ameku M D Doctor Detective S01E11 Drowning in a Dry Room Part 2 1080p AMZN WEB-DL Multi DDP2 0 x264 Anime
Posted by Otaku at April 28, 2025
Ameku M D Doctor Detective S01E11 Drowning in a Dry Room Part 2 1080p AMZN WEB-DL Multi DDP2 0 x264
MKV | 1920x1080 | English / हिन्दी / 日本語 | H264 @ 3170 kbps | E-AC-3 @ 224.0 kbps | 23 min 45 s | 653 MiB
Subtitles: English
MKV | 1920x1080 | English / हिन्दी / 日本語 | H264 @ 3170 kbps | E-AC-3 @ 224.0 kbps | 23 min 45 s | 653 MiB
Subtitles: English
Overlord The Scared Kingdom 2024 1080p ATVP WEB-DL JPN DD5 1 H 264-ToonsHub with subs Anime
Posted by Otaku at April 1, 2025
Overlord The Scared Kingdom 2024 1080p ATVP WEB-DL JPN DD5 1 H 264-ToonsHub with subs
MKV | 1920x1036 | 日本語 | H264 @ 6441 kbps | AC-3 @ 384.0 kbps | 2 h 15 min | 6.44 GiB
MKV | 1920x1036 | 日本語 | H264 @ 6441 kbps | AC-3 @ 384.0 kbps | 2 h 15 min | 6.44 GiB
Ameku M D Doctor Detective S01E05 Crimson Curse of the Sorcerer 1080p AMZN WEB-DL Multi DDP2 0 x264 Anime
Posted by Otaku at April 28, 2025
Ameku M D Doctor Detective S01E05 Crimson Curse of the Sorcerer 1080p AMZN WEB-DL Multi DDP2 0 x264
MKV | 1920x1080 | English / 日本語 / हिन्दी | H264 @ 4335 kbps | E-AC-3 @ 224.0 kbps | 23 min 45 s | 851 MiB
Subtitles: English
MKV | 1920x1080 | English / 日本語 / हिन्दी | H264 @ 4335 kbps | E-AC-3 @ 224.0 kbps | 23 min 45 s | 851 MiB
Subtitles: English
Ameku M D Doctor Detective S01E08 The Night When the Angels Danced Part 1 1080p AMZN WEB-DL Multi DDP2 0 x264 Anime
Posted by Otaku at April 28, 2025
Ameku M D Doctor Detective S01E08 The Night When the Angels Danced Part 1 1080p AMZN WEB-DL Multi DDP2 0 x264
MKV | 1920x1080 | 日本語 / हिन्दी / English | H264 @ 3408 kbps | E-AC-3 @ 224.0 kbps | 23 min 45 s | 694 MiB
Subtitles: English
MKV | 1920x1080 | 日本語 / हिन्दी / English | H264 @ 3408 kbps | E-AC-3 @ 224.0 kbps | 23 min 45 s | 694 MiB
Subtitles: English
Ameku M D Doctor Detective S01E06 Fierce Blazing Finale 1080p AMZN WEB-DL Multi DDP2 0 x264 Anime
Posted by Otaku at April 28, 2025
Ameku M D Doctor Detective S01E06 Fierce Blazing Finale 1080p AMZN WEB-DL Multi DDP2 0 x264
MKV | 1920x1080 | 日本語 / हिन्दी / English | H264 @ 4506 kbps | E-AC-3 @ 224.0 kbps | 23 min 45 s | 880 MiB
Subtitles: English
MKV | 1920x1080 | 日本語 / हिन्दी / English | H264 @ 4506 kbps | E-AC-3 @ 224.0 kbps | 23 min 45 s | 880 MiB
Subtitles: English
Ameku M D Doctor Detective S01E07 Prescribed Poison 1080p AMZN WEB-DL Multi DDP2 0 x264 Anime
Posted by Otaku at April 28, 2025
Ameku M D Doctor Detective S01E07 Prescribed Poison 1080p AMZN WEB-DL Multi DDP2 0 x264
MKV | 1920x1080 | English / 日本語 / हिन्दी | H264 @ 3756 kbps | E-AC-3 @ 224.0 kbps | 24 min 0 s | 761 MiB
Subtitles: English
MKV | 1920x1080 | English / 日本語 / हिन्दी | H264 @ 3756 kbps | E-AC-3 @ 224.0 kbps | 24 min 0 s | 761 MiB
Subtitles: English
Ameku M D Doctor Detective S01E02 Blue Blood Cells and Dragon Fangs 1080p AMZN WEB-DL Multi DDP2 0 x264 Anime
Posted by Otaku at April 28, 2025
Ameku M D Doctor Detective S01E02 Blue Blood Cells and Dragon Fangs 1080p AMZN WEB-DL Multi DDP2 0 x264
MKV | 1920x1080 | 日本語 / हिन्दी / English | H264 @ 4109 kbps | E-AC-3 @ 224.0 kbps | 25 min 15 s | 864 MiB
Subtitles: English
MKV | 1920x1080 | 日本語 / हिन्दी / English | H264 @ 4109 kbps | E-AC-3 @ 224.0 kbps | 25 min 15 s | 864 MiB
Subtitles: English